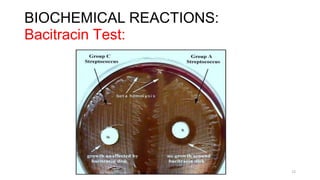
BIOCHEMICAL REACTIONS:
Bacitracin Test:
12
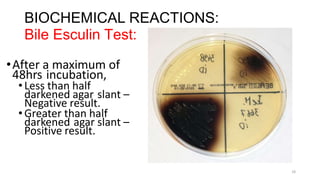
BIOCHEMICAL REACTIONS:
Bile Esculin Test:
•After a maximum of
48hrs incubation,
•Less than half
darkened agar slant –
Negative result.
•Greater than half
darkened agar slant –
Positive result.
16

Streptococcal infections can be caused by a variety of Streptococcus bacteria. Streptococci are classified based on their hemolytic properties and Lancefield antigens. Identification requires examining gram stain morphology, hemolytic patterns, biochemical reactions, and genetic analysis. Pathogenic species like S. pyogenes and S. agalactiae can cause diseases ranging from pharyngitis to necrotizing fasciitis through direct invasion and toxin production. Diagnosis involves culture and identification of the isolated strain. Treatment focuses on appropriate antibiotic therapy.